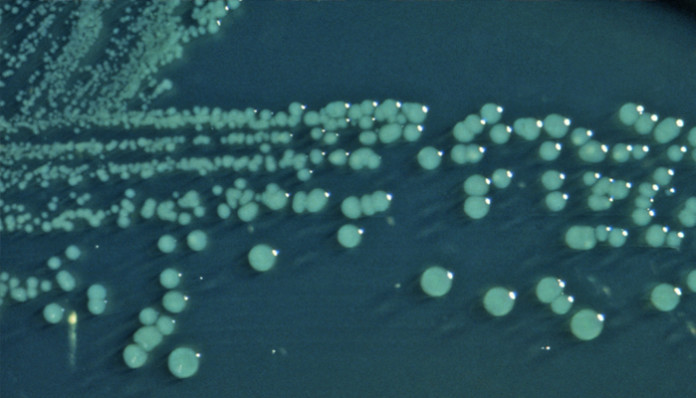

Un grupo de bacterias llamadas Shigella es responsable por mas de 500.000 casos de diarrea en los EE.UU. cada año. Ahora un nuevo informe dice que una cepa resistente a múltiples fármacos está entrando en el país por viajeros infectados y que esta esta causando una serie de brotes.
Shigella causa shigelosis – una enfermedad intestinal que se acompaña de diarrea acuosa o con sangre, dolor abdominal, fiebre y malestar general.
Los Centros para el Control y la Prevención de Enfermedades (CDC) dicen que una cepa de Shigella sonnei – las especies más comunes de Shigella en los EE.UU. – ya es resistente al antibiótico ciprofloxacina (Cipro) esta infecto a 243 personas en 32 estados y Puerto Rico, entre mayo de 2014 y Febrero de 2015.
Shigella es uno de los tipos de bacterias que causan enfermedades intestinales en los viajeros que van desde los países desarrollados a los países subdesarrollados. La «diarrea del viajero», se refiere como «venganza de Moctezuma», o «vientre de Delhi».w
Las bacterias se encuentran en el agua utilizada para beber, para lavar los alimentos o para regar los cultivos, que ha sido contaminada por heces humanas o animales.
Cipro es un fármaco de primera elección para el tratamiento de la shigelosis entre los adultos en los EE.UU.. Hasta hace poco, la resistencia a Cipro sólo se encuentra en alrededor del 2% de las infecciones por Shigella probados en los EE.UU..
En el nuevo informe – que describe las investigaciones de los últimos grupos de la infección por Shigella en Massachusetts, California y Pensilvania – el CDC dicen resistencia Cipro se encontró en el 90% de las muestras analizadas.
Algunas personas infectadas con Shigella sólo tienen síntomas leves, pero esto no impide que el insecto se propague. El informe dice que en estos brotes, las bacterias se propagan fácilmente en los servicios de guardería y entre las personas sin hogar y los hombres homosexuales y bisexuales.
Los investigadores encontraron una cepa de Shigella que es Cipro resistente
Director de los CDC Dr. Tom Frieden dijo que los brotes que investigaron son una tendencia preocupante:
«Las infecciones resistentes a los medicamentos son más difíciles de tratar y por Shigella se propaga tan fácilmente entre las personas, y los brotes son una preocupación real.»
Dr. Frieden afirma los EE.UU. se estan moviendo con rapidez para poner en marcha un plan nacional para frenar la resistencia a los antibióticos, ya que «no podemos dar por sentado que siempre tendremos los medicamentos que necesitamos para luchar contra las infecciones comunes.»
En los EE.UU., la mayoría de las cepas de Shigella ya son resistentes a la ampicilina, trimetoprim / sulfametoxazol. En todo el mundo, Shigella es cada vez más resistente a Cipro, que a menudo se prescribe para personas que viajan fuera de los EE.UU. en caso de que desarrollen diarrea en el extranjero.
El informe describe cómo a través de la red PulseNet laboratorio de los CDC, fue posible identificar un aumento de casos de shigelosis causadas por una cepa única de Cipro resistente Shigella. Alrededor de la mitad de los casos fueron personas que se sabe han regresado de la República Dominicana, la India y otros lugares fuera de los EE.UU..
Los CDC recomiendan buenos hábitos de higiene para evitar la propagación de Shigella, incluyendo:
– Lavarse las manos frecuentemente con agua y jabón
– Lávese siempre las manos con agua y jabón después de ir al baño y antes de preparar alimentos y comer
– Si su hijo está enfermo con diarrea, manténgalo en casa y fuera de las actividades de cuidado de niños y de grupo
– No prepare alimentos para otros si tiene diarrea
– Evite piscinas y otros lugares públicos de agua durante unas semanas mientras se recupera de una enfermedad diarrea.
Dr. Anna Bowen, un oficial médico en base de agua Enfermedades CDC Subdivisión de Prevención, y autor principal del informe, dice:
«Lavarse las manos con agua y jabón es importante para todos. Además, los viajeros internacionales pueden protegerse a sí mismos por la elección de los alimentos calientes y beber sólo de recipientes herméticos.»
Los científicos están empezando a descubrir que el uso de antibióticos – y el uso excesivo sobre todo – está vinculado a una serie de problemas que afectan, entre otras cosas, el sistema inmunitario, el metabolismo de la glucosa, la digestión de alimentos, la salud intestinal y de comportamiento.
es malo fumar una shisha, yigela, farmacos shigela, infecciones intestinales resistentes al trimetropin, marcha para shigella, medicamento de eleccion para tratatar shigella






